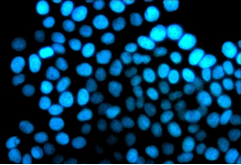

生命学院实验教学管理中心
目录
2015年“实验室开放日”:2015年5月16日对校内外师生、市民、中小学生开放实验室活动32
2016年“实验室开放日”:2016年5月21日对校内外师生、市民、中小学生开放实验室活动33
.2017年“实验室开放日”:2017年5月21日对市民、中小学生开放实验室活动34
2018年“实验室开放日”:2018年5月27日对市民、中小学生开放实验室活动34
生命科学实验教学管理中心从属于永利集团88304官网。
中心历经多年建设:①2002年实验室重点建设项目,投资120万,建成较完善的本科实验条件,设备到位及时,利用率高。能满足生物技术专业和生物工程专业的实验。适应改革后的本学科教学内容所需要的相应条件。并能满足本科生毕业设计所需的实验条件。②2004年学校用于本科教学评估项目,投资174万,2006年全部到位,建设了数码互动、细胞培养、生物化学与分子生物学、细胞与遗传学和微生物学学等7个专业与专业基础课实验室。实验设备已基本满足现有数量的本专业学生需要。小件常用设备满足2~6人/组,大型设备基本满足教学要求。③2009年建设生命科学与工程系科技创新平台,投入10万,完成了生物工程实验平台,为开设发酵工程实验教学提供了良好的条件。④2012年哈工大实验设备处支持教学实验室建设项目,投入26万,补充了部分短缺的仪器设备,优化了资源的配置。尤其超低温冰箱及人工智能培养箱的购买解决了实验物种的保存问题。⑤2013年哈工大实验设备处支持的实验教学中心持续建设项目,投入17万,更新补充了部分短缺的仪器设备,如凝胶成像系统、体式显微镜、微量移液器等。⑥2015年秋哈工大实验设备处支持的实验教学中心持续建设项目,投入21万,更新了部分老化的超期服役的仪器设备,如制冰机、普通光学显微镜、体式显微镜、微量移液器等;补充了一些发酵产物后处理的设备,如超声波细胞破碎仪、柱层析系统、旋转薄膜蒸发仪、台式真空冷冻干燥机等等。⑦2016年在实验设备支持下,投入95.95万,补充了水平电泳槽、垂直电泳槽、显微镜等部分短缺的仪器设备,添置了实时荧光定量PCR仪等高水平仪器设备,提高了实验中心的教学运转效率,并为课程多向改革提供了基础。
建设成果:本科教学实验室具备用于植物生物学、生物化学、动物生物学、普通生物学的生物技术专业实验室,以及一个用于遗传学、细胞生物学教学的标准化实验室和万级洁净度的细胞培养室。拥有用于生命科学实验的主要设备,包括PCR仪、发酵罐、奥林巴斯荧光显微镜,尼康倒置显微镜、超净工作台、离心机、实时定量PCR仪等研究设备。
目前本实验中心每年承担总计16门本科生实验、109个实验项目、540学时;5门研究生实验,13个实验项目,64学时的教学任务,实验开出率100%。已具备能完成学科主要实验教学的多功能性实验室(本科生实验课用实验室371m2)。中心包括以下各实验室(化学楼):
B701 遗传、微生物、细胞生物技术综合实验室
B702 普生、植物、动物生物技术综合实验室
B703 生化、发酵生物工程综合实验室
B704 细胞培养实验室
鹿敏:
全面主持中心建设。负责中心教学管理、中心财务管理、文化建设。
负责的实验教学包括:生物学特色实验、生物大分子分析及检测、生物学实验基础训练、生物技术综合实验,生物化学实验、细胞生物学实验、微生物学实验。
负责教师办公室的安全管理。
梁林:
辅助中心建设。负责中心安全管理及中心现存固定资产中仪器设备管理。
负责的实验教学包括:生物工程综合实验、生物学实验基础训练、生物化学实验。
负责的理论课程教学包括:基础生态学、环境生物工程。
带领并指导生态学野外实习。
负责生物化学实验课程的准备工作。
负责中心703实验室的安全管理
钱宇:
协助并执行中心文化建设,包括网络建设。负责实验室现存固定资产中家具信息的管理。
负责的实验教学课程包括:生物学特色实验、生物大分子分析及检测、生物学基础实验、植物生物学实验、动物生物学实验、遗传学实验、生物工程综合实验。
负责中心设备间的安全管理。
关双红:
协助并执行中心的安全管理。
负责多门实验课程的准备工作,包括:细胞生物学、微生物学、遗传学、生物学实验基础训练、生物学特色实验、现代免疫学技术、细胞分子生物学、微生物遗传学实验。
负责细胞间及701A实验室的安全管理。
黄波:
协助并执行低值易耗品的购买及财务管理。
负责多门实验课程及实习的准备工作,包括:生物学特色实验、生物大分子分析及检测、生物学基础实验、植物生物学实验、动物生物学实验、生物工程综合实验、植物认知实习。
负责中心洗刷间及701B实验室的安全管理。
讲课学时数:8 实验学时数:4
指导教师: 梁林鹿敏 课程编号: LS31057
实验生物的安全:动物、微生物等
实验试剂安全:化学试剂、环境安全
实验操作安全:设备使用、配制试剂的安全


试剂防护 液氮使用安全
2. 生物学基础实验训练二
实验学时数:12
指导教师: 鹿敏 课程编号: LS31058
染色技术-洋葱细胞线粒体的超活染色和细胞骨架的光镜观察
无菌技术-微生物常用培养基的制备与灭菌
显微技术-油镜的使用


洋葱细胞骨架的光镜观察 待灭菌的液体培养基
实验学时数:12
指导教师: 鹿敏 课程编号: LS31059
原代培养
细胞的复苏、传代培养、冻存
实验学时数:24 课程编号:LS31062
指导教师:李丽高艳光鹿敏钱宇
斑马鱼的DNA提取
3T3细胞核的Depi荧光染色
认识环境中的微生物
植物愈伤组织的培养

认识环境中的微生物 荧光显微镜观察DAPI染细胞核图
实验学时数: 24
指导教师: 钱宇 课程编号: LS31002
显微镜的使用技术和细胞的基本结构观察
植物有丝分裂染色体压片技术及有丝分裂周期观察
植物组织的制备及动植物组织结构的观察
动物组织结构的观察
无脊椎动物形态结构观察
蟾蜍的解剖与观察及坐骨神经-腓肠肌标本的制备
血细胞的观察和计数
植物花粉母细胞减数分裂染色体制片与观察

印度橡皮树叶横切 芹菜叶柄横切(示厚角组织)

肺 心脏
蟾蜍解剖图
实验学时数:24
指导教师:鹿敏 课程编号:LS31064
植物DNA的提取及测定
细胞RNA的提取及测定
细胞膜蛋白的提取及测定
实验学时数:24
指导教师:钱宇 课程编号:LS33024
根茎叶的结构
花果实种子的结构
叶绿体色素的提取、分离和含量测定
叶绿体的提取和还原活性的测定
蒸腾速率的测定和影响因素
吲哚乙酸氧化酶活性的测定
植物标本的制作
抗性生理的实验


毛茛老根横切面(部分) 玉米叶横切(部分)
实验学时数: 24
指导教师: 钱宇 课程编号: LS13010
小鼠的解剖与观察
生理信号记录仪的使用与骨骼肌收缩
,心脏的期外收缩与代偿间歇自主性实验,
人体动脉血压的影响因素分析, ,
消化道平滑肌的生理特性分析显微镜的使用
自主性实验


实验用兔 小鼠解剖
实验学时数: 32
指导教师: 梁林 课程编号:生物化学(上)LS13008(生命科学专业)、生物化学(1)LS31003(材料学专业)
蛋白质浓度测定--Folin酚测定法
氨基酸分离鉴定-纸层析法;酶的特性
乳酸脱氢酶(LDH)同工酶的琼脂糖凝胶电泳
鉴定维生素B1、B2、C
纤维素酶活力的测定
血清甘油三酯及胆固醇测定



维生素B1的荧光反应 不同氨基酸纸层析



温度 pH 激活剂与抑制剂
影响酶活力的几种因素
实验学时数: 22
指导教师: 钱宇 课程编号: LS13004
黑腹果蝇的饲养,生活史与突变体的观察
黑腹果蝇的杂交系列实验
人类染色体标本的制作与观察分析
ABO血型鉴定及群体遗传学分析
印记基因


黑腹果蝇雌雄对比 人类外周血淋巴细胞制作的染色体标本

印记鉴定测序峰图
实验学时数: 8
指导教师: 梁林 课程编号: LS31070
植物总DNA的提取
DNA的琼脂糖凝胶电泳与其含量测定
实验学时数: 12
指导教师: 聂桓 课程编号: 13SC14400020
The Characteristics of the Enzyme
DNA extraction
DNA agarose gel electrophoresis and determination
实验学时数: 32
指导教师: 鹿敏 课程编号: LS31006
细菌的染色观察
酵母菌的形态观察及菌体大小测定
霉菌的形态观察及数量测定
微生物的生理生化反应
病毒的分离
环境有机污染物的降解微生物的分离纯化
![]()
![]()
![]()
![]()
![]()

实验学时数: 32
指导教师: 鹿敏 课程编号: LS31007
乳兔组织的石蜡包埋与H.E染色
细胞的融合实验
细胞凋亡的诱导与检测
细胞组分的分级分离及检测


明视野下细胞贴壁生长形态 药物作用48 h AGZY83-a苏木素染色
箭头示凋亡的细胞
实验学时数: 4周
指导教师: 梁林钱宇 课程编号: LS34013
实验大流程及培养基配制
PCR基因扩增与电泳分离DNA片段
PCR产物胶回收及电泳检测
重组DNA分子的制作1:酶切
酶切产物的胶回收及电泳检测
重组DNA分子的制作2:连接
感受态细胞的制备
重组子转化
重组子检测—PCR扩增
质粒DNA的提取和鉴定
重组子转化BL21
重组质粒PCR检测
原核细胞中表达真核基因
SDS-PAGE凝胶电泳检测蛋白表达
BL21菌液扩繁;熟悉发酵罐
发酵罐灭菌、接种、培养
IPTG诱导表达
细胞破碎、离心初步浓缩
层析技术学习,选柱、装柱
层析纯化(上样、收集、检测)
SDS聚丙烯酰胺凝胶电泳检测表达产物
产物精制与保存


流程图 发酵罐
实验学时数: 4周
指导教师: 鹿敏 课程编号: LS34040
实验大流程及培养基配制
PCR基因扩增与电泳分离DNA片段
PCR产物胶回收及电泳检测
重组DNA分子的制作1:酶切
酶切产物的胶回收及电泳检测
重组DNA分子的制作2:连接
感受态细胞的制备
重组子转化
重组子检测—PCR扩增
质粒DNA的提取和鉴定
重组子转化BL21
重组质粒PCR检测
原核细胞中表达真核基因
SDS-PAGE凝胶电泳检测蛋白表达
Western-blot检测蛋白表达

SDS-PAGE凝胶电泳检测蛋白表达
细胞分子生物学是生命科学中的前沿学科,是一门研究细胞结构及其生命活动规律的学科,它所侧重的是细胞时空变化的规律和细胞分子结构功能与结构的整体性,也是生命科学中的重要基础课程。本课程从细胞、亚细胞与分子水平介绍细胞结构和生命活动的规律和机理,介绍分子、物理化学变化在细胞生命活动中的作用,重点讲述细胞的分子结构同生命活动的关系,介绍细胞分子生物学的最新研究进展和动向,让学生建立各种生命活动同细胞结构之间的相互联系的概念和思维方式。通过本课程的实验课教授,提高学生的动手能力,从细胞和分子水平思考、分析问题和解决问题的能力。
实验学时数:16学时
指导教师:赫杰 课程编号:S0628004Q
激光共聚焦显微镜在细胞学中的应用(细胞核、线粒体的细胞化学染色)(包括细胞培养4学时,细胞化学染色4学时)
细胞周期同步化实验(4学时)
流式细胞仪对细胞周期的分析、DNA含量的测定方法(4学时)(科技园2E栋)
当代免疫学技术与应用是在本科免疫学知识基础上开设的一门研究生专业选修课。本课程以实验为主,旨在让学生通过免疫荧光、免疫电镜、酶联免疫反应等实验掌握免疫学实验的基本原理、技术及方法。提高学生的动手能力,达到理论与实践相结合的目的。
实验学时数:30学时
指导教师 赫杰 课程编号:S0628012C
根尖常规电镜包埋实验(包埋、聚合)
铜网铺膜
细胞培养、爬片
微管蛋白的免疫荧光标记
本门课程的目的是使学生(硕、博士研究生)能够掌握微生物遗传学的基本理论、基本技能及其最新发展动态,能够对微生物基因遗传作用机制进行深入了解,让学生具备运用本门课程的基本理论、基本技能进行开创性科学研究的能力,培养出能在微生物领域大显身手的现代生物工程高级科技人才。
课程主要内容:主要介绍微生物遗传学的基本概念、理论及其新发展,微生物遗传的物质基础、基因突变和基因重组、微生物遗传体制、细胞质遗传、基因的作用-结构基因和调控基因、形态建成和分化发育的遗传控制及进化等基本理论和微生物遗传学研究方法。
实验由学生自己设计,提交实验计划,老师批改同意后进行。
实验学时数:12学时
指导教师:宋金柱 课程编号:S0628011Q
细菌营养缺陷型和抗药型的筛选
本门课程的目的是使学生熟练掌握动物细胞传代培养的操作方法,理解平板集落形成实验的原理,理解软琼脂集落形成实验的原理,并掌握分析和统计细胞平板集落和软琼脂集落数量的方法。通过实验掌握细胞工程的技术与原理,提高学生的动手能力,达到理论与实践相结合的目的。
实验学时数:16学时
指导教师:赫杰 课程编号:S0628038Q
平板集落形成实验
软琼脂集落形成实验
实验学时数:12学时
指导教师:丛华 课程编号:S0628039Q
微生物发酵产业化工艺设计基础
微生物发酵工业应用设备的设计与选型
主发酵车间的设计
微生物发酵工业的控制设计
1.实验室设立安全领导小组,负责实验室的安全防火工作,设立安全员负责日常的安全检查,成立防火组织,落实到人。
2.各房间设立安全负责人,负责本室安全工作。班前班后认真检查门、窗、水、电,对发现的不安全因素要及时处理。
3.实验室的钥匙不得出借他人,一旦丢失要及时向领导汇报,以便采取措施,防止意外事故的发生。
4.所有实验室内一律不准吸烟。要经常检查室内电源设备,各种电气设备使用完毕一定要断开电源。下班后要断开室内总电源。机电设备运行中,禁止在各种旋转部位处站人。
5.严禁在易燃、易爆等危险品附近做实验和使用明火,如电炉、酒精灯等。
6.对危险品、剧毒品、放射性物品要指定专人管理。危险物品的领用必须专人审批,限量发放。对剧毒物品的使用过程应予严格控制和监督,对其领、用、剩、废、耗的数量必须详细记录,用剩数量及时退库。危险品的空容器、变质料、废液渣滓应予妥善处理,严禁随意抛弃。
7.使用各种仪器设备都要严格遵守操作规程。用电注意安全,不得违章用电。
8.各实验室要根据实验室的性质及所使用设备的特点,配备必要的消防器材和报警设备。实验室工作人员均应学会正确使用所配的安全器材。安全器材必须定期检查或更换,任何人不得随意搬动、拆改。
9.实验室一旦发生事故,需保护好现场,采取有效措施,并及时报告有关部门。
一、备 课
1.指导教师必须亲自对所有开出的实验项目进行预做实验,并认真写出实验教案。
2.熟悉仪器设备的性能、使用方法以及操作步骤。
二、上 课
1.严格遵守上、下课时间。任课教师要提前至少15分钟到岗,作好实验准备工作并严格按照规定学时数上
课。
2.认真检查学生的预习情况,并对实验要求及主意事项作必要的讲解。
3.教师要注意自身的言传身教作用。应注意培养学生的独立工作能力、分析和解决问题的能力和创新精
神。注意因材施教、教书育人。对学生在实验课堂上的主要表现应有一定记录。
4.学生实验完毕,教师应认真检查实验数据、实验结果。达到要求后,教师应在实验报告原始数据上签
字。
5.课后应协助实验技术人员清点仪器,安排学生将仪器设备按原样整理完毕,清理实验室,打扫卫生。
三、实验报告批改
1.教师必须认真、及时地批改学生的实验报告,对其实验结果与分析给出评语并签字,登记成绩。实验报
告要及时返发给学生。对不合格的报告必须退回,要求学生补做。
2.实验报告成绩应经过合理折算,记入最终课程总成绩。
3.期末负责将学生的实验报告收回,交学院办公室集中保管。
1.按照实验大纲和课表要求准备实验,实验进行中要人在实验室,随时准备解决实验过程中发生的实验技术问题。
2.在每门实验课开课前与实验教师共同完成实验课规定内容的预实验,实验技术人员负责预实验的实验条件与相应的材料的准备。
3.负责生物实验材料的饲养与保存工作。
4.负责本实验室的仪器设备的使用管理,实验前认真检查实验所用仪器是否完好,确保仪器正常工作。实验后及时复查,发现损坏立即更换并维修。
5.每次实验上课前30分钟将实验室打开,实验后检查实验室,确保一切正常。
6.负责本科实验的日常管理工作。每学期前,将下学期实验所需要购置的实验设备和实验药品等上报中心主任。
7.实验技术人员负责本实验室的安全工作,包括钥匙管理、水、电、危险化学药品的管理等。
8.实验技术人员实行坐班制。因实验原因占用休息时间,可用正常工作时间串休。
1.学生必须按时到指定实验室做实验,不得迟到。
2.上课前学生必须对所做的实验进行充分预习,并写出预习报告,经指导教师检查合格后,方可进行实验。
3.学生应独立完成实验准备工作。在启动设备之前,需经指导教师检查认可。
4.实验时,要严肃认真,正确操作,仔细观察,真实记录实验数据的结果。不许喧闹谈笑,不做与实验无关的事情,不动与实验无关的设备,不进入实验无关的场所。
5.实验中要注意安排,遵守实验室安全规定及有关操作规程。
6.仪器设备发生不正常现象时,应及时报告指导教师。发生人身安全事故时,应立即切断相应的电源、气源等,并听从指导教师的指导,要沉着冷静,不要惊慌失措。
7.实验中,如发现仪器设备损坏,应及时报告,查明原因。凡属违反操作规程导致设备损坏的,要追究责任,照章赔偿。
8.学生要进入开放实验室做自行设计的实验时,应事先和有关实验室联系,报告自己的实验目的、内容,并整理好实验现场后,方可离去。
9.实验做完后,需先经指导教师审查数据并签字,然后再将仪器设备按原样整理完毕,清理实验室。在得到教师允许后方可离去。
10.学生必须认真做好实验报告,在规定的时间内交给教师批阅。批阅后的实验报告由学生妥善保管,以备考核。
1.实验教学管理中心里的仪器为全院教学仪器设备,设备分室登记使用,原则上在各实验室固定使用。
2.5万元以上贵重精密仪器设备实行使用前后登记制度,中心人员有权制止违规操作的人员。
3.在各实验室放置的仪器设备,要由该实验室的实验技术人员负责管理。要及时对仪器设备进行擦拭、清理、归位,并请仪器设备负责人验收,确保仪器设备保持清洁、正常状态。
4.不允许违规独自操作使用仪器设备,要由指导教师和任课教师负责指导使用。使用完毕后,由指导教师和任课教师检查仪器设备的的情况。
5.对一些高压、高温、明火等仪器设备的使用,运行前,使用人一定要专门详细检查设置程序,确保安全使用。有明火的仪器设备要妥善使用、妥善保管,用完后待其冷却后方可收置。
6.任何进实验室的、在本中心实验室进行实验的人员,要学习相关的实验室安全教育。非本院的学生和人员在实验室做实验须到实验室负责人员处登记备案。
7.要节约使用实验所需的材料。用完后不准乱堆乱放,用后及时清洗,试剂要放回原处,使实验室恢复实验前的状态。
8.需要维护、维修的仪器设备,及时上报中心主任。
1.仪器设备发生损坏丢失(含附件和技术资料)均属设备事故,设备事故分为责任事故和非责任事故,凡属人为因素造成的仪器设备损坏丢失为责任事故,凡因遭受灾害,不可抗拒事件以及设备的自然损坏均为非责任事故。在各实验室的人员都有责任避免事故的发生。
2.因责任事故造成设备器材损坏丢失的均应赔偿,在考虑赔偿的轻重时将根据具体情节、不同对象、物资性质、本人一贯表现、事后的态度及损坏丢失设备价值的大小具体分析、区别对待。
3.发生事故后,要及时上报实验室负责人员。
4.本科教学实验中发生责任事故的,中心承担损坏价值的70%,由任课教师和学生协商承担30%。
5.其他未尽事项,按学校相关制度办法执行。
为了促进实验教学改革,加强对学生实践能力和创新能力的培养,充分发挥实验室在实施素质教育中的重要作用,提高实验仪器设备的有效利用率,特制定本办法。
凡有意愿进入中心实验室开展实验活动的院外学生,应提前三周申报实验计划,并如实填写《永利集团88304官网实验教学中心开放实验申请表》,经学生所在院(系)同意后,报请实验教学中心承接,并由实验中心以申请人为单元、在保证教学工作的基础上,填写《永利集团88304官网实验教学中心学生开放实验预约登记表》,确定学生具体实验时间。
中心根据教学实际和学生申报情况按需安排指导教师,辅助实验器材,安排实验场所。
对于院内学生,按实验类型、实验要求做好实验准备,设计并提交实验方案,包括设备器材药品时间辅助等方面的需求,经指导教师认可后才能进行实验。
学生进入实验室应严格遵守实验室的各项规章制度,在实验指导教师、技术人员的指导下进行实验活动,并认真撰写实验报告,对实验项目的创新点、实验数据的采集记录、实验操作过程、实验结果、收获与体会等进行总结。实验报告应由实验指导教师或实验技术人员批阅签字,作为对开放实验室进行考核的依据。
在开放实验项目中指导学生实验的实验教师和技术人员工作量(不含正常教学工作量),由中心负责人于每学期末对本学期工作量按教学工作量进行核算认定,其中开放实验在业余时间(含假期)内的实验工作量按正常实验工作量的1.2倍计算。
联系电话:86402052(明德楼710室)
联系人:鹿敏
如有高端科研需求,请联系永利集团88304官网公共设备平台http:/news/main.asp?cataid=A00330005
地址:哈工大科学院2E栋
联系电话:86403165
联系人:曲有朋
永利集团88304官网
实验教学管理中心

生物学基础实验训练三
特色实验
细胞生物学
遗传学
微生物学
研究生实验课程
细胞分子生物学实验、当代免疫学技术与应用、微生物遗传学——细菌营养缺陷型和抗药型的筛选、细胞工程技术与原理
生物学基础实验训练一
生物学基础实验训练二
特色实验
普通生物学实验
植物生物学及实验
动物生物学及实验
生物技术综合实验
生物化学
生物工程综合实验
研究生实验:微生物发酵工程产业设计
每位培养室的使用者要登记预定使用时间、内容,并做到:
1.进入培养室之前,换专用实验服和实验拖鞋、洗手并用酒精消毒。不允许将个人无关物品带入培养室。
2.保持室内的清洁卫生。将物品放入超净台之前要消毒;每次使用后,要将所涉及的台面、桌面和地面
擦拭干净并消毒。
3.保持室内用品的清洁和摆放整齐。
4.使用过的培养瓶、吸管、离心管等用清水冲洗干净后,浸泡到指定的容器内。
5.根据自己的实验需要,准备好所需物品,严禁随意拿用他人物品。
6.定期对室内的地面、桌面、培养箱内部、仪器等进行清洁和消毒(每周至少一次)。
7.如发现任何问题及时处理并汇报,否则追究其责任。
8.在未经允许,擅自进入培养室者,将对发生的可能事件负全部责任。

生命学院本科生
生命学院研究生
材料学院光电信息专业本科生
计算机学院生物信息技术专业本科生
其他选修学生,如双学位
交换学生
实验室对本科实验课学生开放,考虑到生物材料和试剂很难做到随时可用,以及后续实验安排的困难,无法做到任何时间做任意实验,但实验课的同学如果时间安排困难,可以和老师协调,换到其他时间的小组,甚至预约本次实验附近的时间段单独实验。
实验室也对研究生开放,每年为约30人、64学时的细胞分子生物学实验、细胞工程技术与原理、微生物遗传学实验、当代免疫学技术与应用实验服务。
本实验教学管理中心除对实验课学生开放,其他师生如有实验要求,也可以和本中心主任联系,提交实验方案,包括设备器材药品时间辅助等等方面的需求,本中心会在保证教学工作的基础上给予考虑。例如2014寒假第一周面向全校同学开放的代表性实验,2015年开展的实验室开放日。
联系电话:86402052(化工楼B710室);Email: lianglin@hit.edu.cn
另,本院生化中心公共实验室(哈工大科学园2E栋)有很多大型的高端的成套的设备(http:/news/main.asp?cataid=A00330005),对校内校外师生开放,联系方式:岳磊,电话86403165.
本实验教学管理中心会在保证教学工作的基础上,为学生创新实验提供场所、器材、指导等帮助,服务大学生创新创业计划,为学生各种竞赛提供服务。
总表
课程名称 | 课程编号 | 实验 学时 | 实验 要求 | 是否 开放 | 项目 总人数 | 指导教师 姓名 | 指导教师 职称 | 实验课地点 | 联系电话 |
生物学基础实验训练一 | LS31057 | 12 | 必修 | 否 | 43 | 梁林,鹿敏 | 工程师 | 明德楼701、702 | 86402052 |
生物学特色实验 | LS31062 | 24 | 必修 |
| 43 | 李丽等 | 副教授 | 明德楼701、702 | 86402052 |
动物生物学及实验 | LS33026 | 24 | 选修 | 否 | 27 | 钱宇 | 工程师 | 明德楼702 | 86402052 |
生物化学 | LS31003 LS13008 | 32 | 必修 | 否 | 45 | 梁林 | 工程师 | 明德楼703 | 86402052 |
遗传学 | LS31004 | 22 | 必修 | 否 | 24 | 钱宇 | 工程师 | 明德楼701 | 86402052 |
细胞生物学 | LS31007 | 32 | 必修 | 否 | 31 | 鹿敏 | 高级工程师 | 明德楼701 | 86402052 |
生物化学B | LS31070 | 8 | 必修 | 否 | 8 | 梁林 | 教授 | 明德楼703 | 86402052 |
详表
生物学基础实验训练一
序号 | 项目名称 | 学时 | 节次 | 任课教师 | 地点 |
1 | 实验室安全意识 | 2 | 第1周,周一,13:45-15:30 | 梁林 | 明德B703 |
2 | 实验室消防安全、电气安全 | 2 | 第1周,周二,13:45-15:30 | 梁林 | 明德B703 |
3 | 实验室化学安全 | 2 | 第1周,周四,13:45-15:30 | 梁林 | 明德B703 |
4 | 实验室生物安全 | 2 | 第1周,周六,10:00-11:45 | 梁林 | 明德B703 |
5 | 实验室生物安全 | 2 | 第1周,周五,13:45-15:30 | 梁林 | 明德B703 |
6 | 生物试剂配制 | 4 | 第1周,周六,13:45-15:30 | 鹿敏 | 明德B703 |
7 | 生物试剂配制 | 第1周,周二,15:45-17:30 | 鹿敏 | 明德B703 | |
8 | 生物试剂配制 | 第1周,周四,15:45-17:30 | 鹿敏 | 明德B703 | |
9 | 生物试剂配制 | 第1周,周五,15:45-17:30 | 鹿敏 | 明德B703 |
生物学特色实验
序号 | 项目名称 | 学时 | 时间 | 任课教师 | 地点 |
1 | 环境微生物检测 | 6 | 第2周,周二,13:00-18:10 | 鹿敏 | 明德B701 |
第2周,周四,13:00-18:10 | |||||
第2周,周六,13:00-18:10 | |||||
第2周,周日,13:00-18:10 | |||||
2 | 模式动物斑马鱼实验 | 6 | 第4周,周二,13:00-18:10 | 李丽 鹿敏 | 明德B701 |
第4周,周四,13:00-18:10 | |||||
第4周,周六,8:00-11:30 | |||||
第4周,周日,8:00-11:30 | |||||
3 | 植物组培实验 | 6 | 第6周,周一,13:00-18:10 | 钱宇 | 明德B702 |
第6周,周二,13:00-18:10 | |||||
4 | 荧光显微镜观察DAPI染细胞核 | 6 | 第7周,周二,13:00-18:10 | 高艳光 鹿敏 | 明德B701 |
第7周,周四,13:00-18:10 | |||||
第7周,周六,13:00-18:10 | |||||
第7周,周日,13:00-18:10 |
动物生物学及实验
序号 | 项目名称 | 学时 | 时间 | 任课教师 | 地点 |
1 | 小鼠的解剖与观察 | 4 | 第8周,星期三,13:00-16:20 | 钱宇 | 化学楼B-702 |
第8周,星期四,13:00-16:20 | |||||
2 | 生理信号记录仪的使用与骨骼肌收缩 | 4 | 第9周,星期三,13:00-16:20 | 钱宇 | 化学楼B-702 |
第9周,星期四,13:00-16:20 | |||||
3 | 心脏的期外收缩与代偿间歇 | 4 | 第12周,星期三,13:00-16:20 | 钱宇 | 化学楼B-702 |
第12周,星期四,13:00-16:20 | |||||
4 | 人体动脉血压的影响因素分析 | 4 | 第13周,星期三,13:00-16:20 | 钱宇 | 化学楼B-702 |
第13周,星期四,13:00-16:20 | |||||
5 | 消化道平滑肌的生理特性分析 | 4 | 第14周,星期一,13:00-16:20 | 钱宇 | 化学楼B-702 |
第14周,星期一,13:00-16:20 | |||||
6 | 自主性实验 | 4 | 第15周,星期三,13:00-16:20 | 钱宇 | 化学楼B-702 |
第15周,星期四,13:00-16:20 |
生物化学
序号 | 项目名称 | 学时 | 时间 | 任课教师 | 地点 |
1 | 蛋白质浓度测定--Folin酚法 | 4 | 第8周,周四,13:45-17:15 | 梁林 | 明德B703 |
第8周,周五,13:45-17:15 | |||||
第周,周六,8:00-11:30 | |||||
2 | 氨基酸分离鉴定-纸层析法;酶的特性 | 5 | 第9周,周四,13:45-17:15 | 梁林 | 明德B703 |
第9周,周五,13:45-17:15 | |||||
第9周,周六,8:00-11:30 | |||||
3 | 乳酸脱氢酶(LDH)同工酶的琼脂糖凝胶电泳 | 8 | 第10周,周四,13:45-17:15 | 梁林 | 明德B703 |
第10周,周五,13:45-17:15 | |||||
第10周,周六,8:00-11:30 | |||||
4 | 鉴定维生素B1、B2、C | 4 | 第11周,周四,13:45-17:15 | 梁林 | 明德B703 |
第11周,周五,13:45-17:15 | |||||
第11周,周六,8:00-11:30 | |||||
5 | 纤维素酶活力的测定 | 3 | 第12周,周四,13:45-17:15 | 梁林 | 明德B703 |
第12周,周五,13:45-17:15 | |||||
第12周,周六,8:00-11:30 | |||||
6 | 血清甘油三酯及胆固醇测定 | 4 | 第13周,周四,13:45-17:15 | 梁林 | 明德B703 |
第13周,周五,13:45-17:15 | |||||
第13周,周六,8:00-11:30 | |||||
7 | 细胞RNA的提取及测定 | 4 | 第14周,周四,13:45-17:15 | 梁林 | 明德B703 |
第14周,周五,13:45-17:15 | |||||
第14周,周六,8:00-11:30 |
遗传学
序号 | 项目名称 | 学时 | 时间 | 任课教师 | 地点 |
1 | 黑腹果蝇的饲养,生活史与突变体的观察 | 4 | 第4周,星期三,13:00-16:20 | 钱宇 | 化学楼B-701 |
第4周,星期四,13:00-16:20 | 化学楼B-701 | ||||
2 | 黑腹果蝇的杂交系列实验 | 4 | 第6周,星期三,13:00-16:20 | 钱宇 | 化学楼B-701 |
第6周,星期三,13:00-16:20 | 化学楼B-701 | ||||
3 | 人类染色体标本的制作与观察分析 | 5 | 第7周,星期三,13:00-17:10 | 钱宇 | 化学楼B-701 |
第7周,星期四,13:00-17:10 | 化学楼B-701 | ||||
4 | ABO血型鉴定及群体遗传学分析 | 2 | 第10周,星期三,13:00-14:40 | 钱宇 | 化学楼B-701 |
第10周,星期四,13:00-14:40 | 化学楼B-701 | ||||
5 | 印记基因 | 7 | 第13周,星期六,13:00-18:10 | 钱宇 | 化学楼B-701 |
第13周,星期日,13:00-18:10 | 化学楼B-701 |
细胞生物学
序号 | 项目名称 | 学时 | 时间 | 任课教师 | 地点 |
1 | 乳兔肾脏细胞的原代培养 | 4 | 第8周,周一,13:00-18:10 | 鹿敏 | 明德楼B-701 |
第8周,周二,13:00-18:10 | |||||
2 | 细胞组分的分级分离 | 5 | 第9周,周一,13:00-18:10 | 鹿敏 | 明德楼B-701 |
第9周,周二,13:00-18:10 | |||||
3 | 细胞组分的检测 | 5 | 第10周,周一,13:00-18:10 | 鹿敏 | 明德楼B-701 |
第10周,周二,13:00-18:10 | |||||
4 | 细胞的传代培养与活细胞计数、冻存与复苏 | 8 | 第10周,周日,8:00-11:30 | 鹿敏 | 明德楼B-701 |
第11周,周二,13:00-18:10 | |||||
5 | 细胞的融合实验 | 4 | 第12周,周一,13:00-18:10 | 鹿敏 | 明德楼B-701 |
第12周,周二,13:00-18:10 | |||||
6 | 细胞凋亡的分析与检测 | 6 | 第13周,周一,13:00-18:10 | 鹿敏 | 明德楼B-701 |
第13周,周二,13:00-18:10 |
生物化学B
序号 | 项目名称 | 学时 | 时间 | 任课教师 | 地点 |
1 | 植物总DNA的提取 | 4 | 第15周,周六,8:00-11:30 | 梁林 | 明德B703 |
第15周,周日,8:00-11:30 | |||||
第16周,周六,8:00-11:30 | |||||
2 | DNA的琼脂糖凝胶电泳及其含量测定 | 4 | 第15周,周六,13:45-17:15 | 梁林 | 明德B703 |
第15周,周日,13:45-17:15 | |||||
第16周,周六,13:45-17:15 |
电话:86402052(明德楼B710室)
Email:lianglin@hit.edu.cn
QQ群:2281900041(HIT生命学院实验课)
可摄像光学生物显微镜 | |
| 产品特点
1.可配三目筒 2.4位物镜转换,4x, 10x, 40x, 100x平场消色差物镜 3.无限远光路 4.EZStore具有手柄和绳裹,便于显微镜搬运,并保护显微镜部件免受损坏
应用范围 生物,教学,科研等
生产厂家 徕卡 型 号 DM500+ICC505 |
生物洁净工作台(Clean bench) | |
| 产品特点 1.垂直单向流形,闭合工作台面,可有效防止外部气流诱入及操作异味对人体的剌激。 2.采用可调风量风机系统,轻触型开关,调节电压大小,保证工作区风速始终处于理想状态 。 3.工作台面为进口不锈钢材质,美观耐 用。箱体表面采用静电喷涂。 4. 前后门采用配重平衡,可随意升降。 应用范围 用于细胞学、分子生物学等操作人员在无菌的条件下进行工作 生产厂家:哈尔滨市东联电子技术开发有限公司 型 号:DL-CJ-2F |
体视显微镜(Stereo Microscope) | |
| 产品简介 1.高清晰度、高分辨率的立体图像 2.1X到4X的连续变倍确保像面的齐焦性 3.双侧水平变倍手轮使用舒适灵活 4.压铸的金属结构保证整体质量的稳定、统一 5.双目视度可调 6.瞳距在55-76mm之间可调 7.可选择的放大范围: 8.从2.5X-10X(5X广角目镜和0.5X辅助物镜) 9.到30X-120X(20X广角目镜1.5X辅助物镜) 10.可选择的工作距离:从133mm(0.5X附加物镜)到33mm(1.5X附加物镜 生产厂家:Motic |
微量移液器(Pipetman) | |
| 量程 0.2-2ul 2-20ul 20-200ul 100-1000ul
应用范围 液体试剂的微量移取
生产厂家:热电 Thermo
型 号:F2 |
紫外可见分光光度计(UV/Visible spectrophotometer) | |
| 产品规格 仪器主要技术指标 1. 波长范围:200~800nm。 2. 波长精度:≤±2nm 3. 波长重现性:1nm 4. 光度范围:0~100% 0~1.999(A) 0~2000(C) 5. 透过率精度: ±0.5 %(T) 6. 透过率重现性: ±0.3%(T) 7. 杂散光: <0.5%(用NaI溶液在220nm处,用NaNO2溶液在360nm处) 8. 稳定性 暗电流漂移: 0.2%(T)/3min在0%(T)处 光电流漂移: 0.5%(T)/3min在100%(T)处 9. 光谱带宽:5nm 10. 电源:220V±10% 50Hz±1Hz 11. 接收元件:端窗式GD33型光电管 产品优点 采用优质刻划光栅,使仪器的杂散光降低到比较理想的水平,从而提高了仪器的测光精度和灵敏度。 应用范围 依据相对测量原理,对液体或透明固体作定性和定量分析。 生产厂家:江苏扬中绿扬分析仪器厂 型 号:752 UV/Visible |
电泳系统(Bio-rad Electrophoresis System) | |
| 技术指标 1. 一次性的水化盘设计使得水化后的胶条转移到聚集盘上变得非常简便,这样,残留的样品缓冲液不会影响电流通过胶条 2.胶条在托盘上的安放是对号入座,简化实验操作 3.可以进行实验方法的预设及实时的编辑,友好的操作界面方便了对实验方法的编程和实验步骤的及时增添 4.具有RS-232串口,可外接打印机,打印实验方法和数据 产品特点 可用于IEF和多块PAGE胶的电泳及电泳印迹 生产厂家:Bio-rad 型 号:Power/PAC 1000 PROTEAN II |
高速小型台式离心机(High speed small desktop centrifuge) | |
| 高速小型台式离心机 ( Sigma 1-13 ) 技术指标 · 最大转速:13,000rpm · 最大容量:16×2.2和16×0.75ml · 最大离心力:11,340g · 时间控制:0~1.5min/连续/短时运转 · 噪音:<53dBA · 重量:5.2Kg · 尺寸(D×W×H):265mm×215mm×175mm 应用范围 主要应用于对生物细胞、蛋白、悬浮液及胶体溶液等样品进行分离、浓缩、提取等。 生产厂家:德国Sigma 型 号:1-13 |
超纯水制造系统(Ultrapure Water Purification Systems) | |
| 仪器工作原理 将自来水作初步处理,一般包括预过滤(深层过滤及膜过滤)和反渗透或蒸馏法,而反渗透因其污染物去除率达到90%~95%以上,将纯水作超纯化处理,出水水质可以达到电阻率:18.2MΩ·cm,总有机物<10ppb,配合不同设计的超纯化柱,能有效去除水中的热源及有机物,适合所有高灵敏度实验的要求。 主要功能 Milli-Q Synthesis 是所有从事化学分析、生化研究及细胞培养所不可缺少的,该系统以反渗透水、蒸馏水、Elix水或去离子水为进水,随时提供符合美国材料试验学会(ASTM)、美国病理学会(CAP)和临床医学会(NCCLS)规定的I级(试剂级)超纯水。 应用范围 利用该仪器制备的超纯水可满足实验室普通应用,也可用于分析化学、 生命科学、分子生物学以及超痕量分析。 生产厂家:Millipore corporation 型 号:Milli-Q Synthesis |
热循环仪(Eppendorf Mastercycler) | |
| 简要介绍 Eppendorf Mastercycler 热循环仪依靠先进的“珀尔帖”技术控制加热和冷却功能,温度控制范围在4~99 ℃之间,带液晶显示屏,程序控制简单。该热循环仪安有RS-232端口和打印机接口。内储存器能存上百万个不同操作程序,程序可在不同Mastercycler热循环仪之间互传。 应用范围 适合用于快速基因扩增试验。通用加热板能容纳96个0.2毫升的试管,77个0.5毫升试管或一个96 孔板。控制程序能自动校对标准温度参数,PCR试验启动、暂停、再启动操作简便。 生产厂家:德国艾本德股份公司(Eppendorf) 型 号:Mastercycler 5333 |
自动立式灭菌器(STAINLESS STEEL VERTICAL DISTILLING APPARTUS) | |
| 仪器特点 灭菌器主要部件及灭菌室均采用不锈钢材料制成,适用于器械、敷料、食品、器皿、药液、培养基等物品灭菌,其性能特点:操作简便、灭菌干燥彻底,《自控型》具有断水保护装置及指示灯显示工作状态,《自动型》根据设定温度、时间将有电脑控制工作程序并液晶显示工作状态。本仪器结构先进、安全可靠,是各医疗卫生、食品化工、科研单位实验室理想的灭菌设备。 主要功能 超温自动保护装置:超过设定温度,系统自动切断电源; 门安全联锁装置:内室有压力,门无法打开; 超压自动泄压的安全阀:超过设定压力,安全阀打开; 温度在100~134℃可调。 应用范围 主要用于微生物及分子生物学的培养基、玻璃器皿以及其它可耐受压力蒸汽作用物品的灭菌。 生产厂家:上海申安医疗器械厂 型 号:LDZX-40A1 |
凝胶成像系统(天能UV-2000) | |
| 凝胶成像即对dna/rna/蛋白质等凝胶电泳不同染色(如eb、考马氏亮蓝、银染、sybr green)及微孔板、平皿等非化学发光成像检测分析。凝胶成像系统可以应用于分子量计算,密度扫描,密度定量, PCR定量等生物工程常规研究。 主要参数: 有效像素1280×1040;像素密度8 bit (256色);像素尺寸5.2um×5.2um;无像素合并;信噪比≥56db;灵敏度低于20pgEB染色的双链DNA;电动变焦镜头Computar M6Z1212M 2/3英寸大口径高通透镜头, F=1:1.2,12.5~75mm主流电脑1台配置:19英寸显示屏、Intel 奔腾双核 G63处理器、2G内存、500G硬盘、DVD光驱、Windows 7 Home Bas操作系统。 |
荧光定量PCR仪 | |
| 本设备采用 珀耳帖效应热循环系统,48孔加热块,支持容量10–30μL 。 样本升降温速率:快速模式为±2.2℃/秒,标准模式为±1.6℃/秒 ;加热块高升降温速率:4.6℃/秒。 温度范围4℃-100℃,温度精度:设置值/显示温度的±0.25℃(35℃至95℃)(时钟启动后3分钟开始测量),温度均一性:±0.5℃(35℃至95℃)(时钟启动后30秒开始测量)。熔解曲线分辨率低至0.1°C 。 光学系统为LED激发光源、发射滤光器、光电二极管,安装时已校准染料SYBR® Green I、FAM™、VIC®、JOE™、ROX™ 染料,被动参照染料ROX™染料,数据采集对所有反应孔收集所有滤片的数据(无论何种反应板设置),试验结束后反应板设置可修改。 定量PCR分析时间:标准模式不超过2小时,快速模式不超过40分钟。 LCD/6.5英寸VGA (640×480)/32K色触摸屏。 应用软件(基于标准曲线的定量、相对标准曲线、基于比较Ct值的相对定量、融解曲线分析、存在/不存在、基于或非基于实时扩增的基因分型),引物分析软件3.0(用于客户自行设计引物和探针) |
荧光光学生物显微镜 |
|
| 仪器特点 UIS2无限远光学系统 垂直移动载物台:载物台行程25mm,带有粗带调限位器,粗调旋钮可以调节扭矩。 载物台安装位置可变,具有(本信息来自普赫光电)高敏感度的微调旋钮(最小调焦精度:1微米) 内置透射光柯勒照明器,光强预设按钮,光强管理开关,高色彩再现性14W LED光源(亮度:相当于或比100W卤素灯更亮,LED发光方式:405nm激发RGB荧光物质)。 可更换的5孔/5孔编码/6孔/7孔/7孔编码物镜转盘 宽视场(视场数22) 陶瓷表面同轴载物台,带有左手或(本信息来自普赫光电)右手低位驱动装置;带有旋转装置和扭矩调节装置。 1O0W复消色差汞(本信息来自普赫光电)灯灯室和供电器,100瓦普通汞灯灯室和供电器,75瓦氙灯灯室和供电器 应用范围 细胞或微小生物的荧光染色观察 生产厂家 奥林巴斯 型 号 BX53荧光+DP73+ |
另,本院生化中心公共实验室(哈工大科学园2E栋)有很多大型的高端的成套的设备(http:/news/main.asp?cataid=A00330005),对校内校外师生开放,联系方式:曲有朋,电话86403165.
①2002年实验室重点建设项目,投资120万,建成较完善的本科实验条件,设备到位及时,利用率高。能满足生物技术专业和生物工程专业的实验。适应改革后的本学科教学内容所需要的相应条件。并能满足本科生毕业设计所需的实验条件。
②2004年学校用于本科教学评估项目,投资174万,2006年全部到位,建设了数码互动、细胞培养、生物化学与分子生物学、细胞与遗传学和微生物学学等7个专业与专业基础课实验室。实验设备已基本满足现有数量的本专业学生需要。小件常用设备满足2~6人/组,大型设备基本满足教学要求。
③2009年建设生命科学与工程系科技创新平台,投入10万,完成了生物工程实验平台,为开设发酵工程实验教学提供了良好的条件。
④2012年哈工大实验设备处支持教学实验室建设项目,投入26万,补充了部分短缺的仪器设备,优化了资源的配置。尤其超低温冰箱及人工智能培养箱的购买解决了实验物种的保存问题。
⑤2013年哈工大实验设备处支持的实验教学中心持续建设项目,投入17万,更新补充了部分短缺的仪器设备,如凝胶成像系统、体式显微镜、微量移液器等。
仪器设备名称 | 型号 | 台套数 |
易燃品、毒害品储存柜 | 浙江联盈LY-DPG02 | 1 |
微量移液器 | 热电 | 25 |
紫外割胶仪 | 天能UV-2000 | 1 |
凝胶成像系统 | 天能Tanon 1600 | 1 |
垂直电泳槽 | 天能VE-180 | 4 |
体式显微镜 | 麦克奥迪实业集团有限公司 | 5 |
恒温水浴锅 | 泰斯特DK-98-IIA智能型 | 2 |
磁力搅拌器 | 其林贝尔 | 2 |
磁力搅拌器 | IKA 数显 | 2 |
电泳仪 | 伯乐 | 1 |
液氮罐 | 成都金凤液氮容器有限公司 | 1 |
液氮罐 | 成都金凤液氮容器有限公司 | 1 |
⑥2015年秋哈工大实验设备处支持的实验教学中心持续建设项目,投入21万,准备更新部分老化的超期服役的仪器设备,如制冰机、普通光学显微镜、体式显微镜、微量移液器等;补充一些发酵产物后处理的设备,如超声波细胞破碎仪、柱层析系统、旋转薄膜蒸发仪、台式真空冷冻干燥机等等。其中制冰机、超声波细胞破碎仪、冷冻冷藏冰箱已经购置,其余仪器将于2016春季学期购置。
仪器设备名称 | 型号 | 台套数 |
紫外分光光度计 | 上海元析 UV5100 | 4 |
小型台式离心机 | sigma 1-14 | 2 |
微量移液器 | 热电 | 5 |
光学显微镜 | 麦克奥迪 BA210 | 5 |
体式显微镜 | 麦克奥迪实业集团有限公司 | 2 |
水平电泳槽 | 北京君意东方JY-SPAT | 5 |
制冰机 | Grant制冰机 | 1 |
超声波细胞破碎仪 | JY92-IIN超声波细胞粉碎机 | 2 |
柱层析系统 | HC99-3 自动核酸蛋白分离层析仪 | 1 |
旋转薄膜蒸发仪 | RE-52CS高效旋转蒸发器 | 4 |
实验室台式真空冷冻干燥机 | FD-1D-50 | 1 |
冷冻冷藏冰箱 | 海尔BCD-241WDCV | 1 |
真空抽滤装置 | ES-08无油活塞真空泵+1000ml(过滤装置)抽滤装置 | 4 |
⑦2016年秋哈工大实验设备处支持的实验教学中心持续建设项目,投入95万,除了进一步更新现有设备,还增加了适应新技术新要求的荧光光学显微镜,梯度热循环仪,实时荧光定量PCR仪等,满足充实实验课,并深化改革的需要。
设备名称 | 型号 | 新选台套数 |
荧光光学生物显微镜 | 奥林巴斯BX53荧光+DP73 | 1 |
梯度热循环仪(PCR) | Mastercycler pro | 1 |
实时荧光定量PCR仪 | StepOne(ABI) | 1 |
样品混匀仪 | IKA Trayster | 2 |
电泳仪 | 北京君意东方JY600 | 7 |
水平电泳槽 | 北京君意东方JY-SPAT | 13 |
垂直电泳槽 | 天能VE-180电泳槽 | 6 |
体视显微镜 | 奥林巴斯SZ51 | 13 |
可摄像体视显微镜 | 徕卡EZ4W | 1 |
小型台式离心机 | sigma1-14 | 2 |
pH计(酸度计) | 赛多利斯PB-10 | 2 |
超净工作台 | SW-CJ-2F 双人双面超净工作台 | 2 |
可摄像光学生物显微镜 | 徕卡DM500+ICC50 | 5 |
光学生物显微镜 | 奥林巴斯CX23 | 10 |
实验室高压均质机 | Scientz-150 | 1 |
实验室名称 | 开放内容(实验项目) | 学时 | 教学目的(实验要求) | 开放预约方式 (电话或预约网址) | 实验室 地点 | 开放时间 | 联系人 | 联系电话 |
生物化学与分子生物学实验室 | 提取植物总DNA、DNA凝胶电泳 | 4 | 掌握CTAB法从植物叶片中快速提取基因组DNA; 掌握DNA琼脂糖凝胶电泳原理与方法。 | L406 | 2014.1.12 8:00-11:20 | 梁林 | 18345174418 | |
细胞培养室 | 细胞的传代培养 | 4 | 了解如何扩大培养细胞 | L413 | 2014.1.13 8:30-11:50 | 鹿敏 | 18645006225 | |
微生物学实验室 | 霉菌的形态观察 | 4 | 认识常见微生物形态 | L408 | 2014.1.14 8:30-11:50 | 鹿敏 | 18645006225 | |
遗传学实验室 | 植物基本结构-细胞表皮 | 2 | 了解细胞基本结构 | L404 | 2014.1.15 8:00-9:40 | 钱宇 | 13766870297 | |
遗传学实验室 | 人体血压影响因素分析 | 3 | 了解人体血压测量方式与影响血压的因素 | L404 | 2014.1.15 10:00-12:30 | 钱宇 | 13766870297 | |
遗传学实验室 | 果蝇的雌雄鉴别 | 3 | 学习鉴别果蝇性别的方法 | L404 | 2014.1.16 8:00-10:30 | 钱宇 | 13766870297 |
为提高公众科学素养,积极响应科技部、中央宣传部、中国科协共同举办2015年科技活动周的号召,2015年5月16日在哈工大生命学院举办了主题为“接近‘生命’,热爱科学”的“实验室开放日”科学普及活动,本次活动由中国细胞生物学学会、黑龙江省细胞生物学学会联合主办,永利集团88304官网生命学院承办,当天共有超过130位市民参与了活动,他们中包括中小学生、大学生及市民参观者,年龄最小的孩子不足6岁。
实验项目 | 房间 | 设备 |
1. 显微镜观察微生物菌种 | 408 | 显微镜 |
2. 果蝇 | 406 | 体视显微镜 |
3. 植物标本、显微镜观察植物切片 | 404 | 显微镜 |
4. 荧光显微镜观察斑马鱼、PPT讲解 | 409 | 荧光显微镜 |
5. 科普短片 | 401 | 投影仪 |
6. 四楼走廊展示各实验室展板 |
活动受到了广大市民及媒体的热议和好评,在全市范围产生了“学科学、爱科学”的正面影响。黑龙江日报、晨报、东北网、人民网等多家媒体采访报道,黑龙江省教育厅官网、新华网、搜狐网、中国日报、东方网等多家媒体转载,并有媒体表示希望进一步报道与百姓生活息息相关的生命科学研究进展,活动结束后永利官网仍接到了多位来自高校教师及科研院所研究人员的进一步咨询。
相关报道:
哈工大报 | “实验室开放日”活动吸引众多市民参观 | |
校内快讯 | 媒体热议2015年生命科学“实验室开放日” | |
黑龙江日报 新华网 | 哈工大开放实验室供市民参观 | http://www.hlj.xinhuanet.com/news/2015-05/17/c_134245592.htm |
新民网 | 哈工大开放实验室供市民参观 |
为提高公众科学素养,发挥学术团体的社会职能,黑龙江省细胞生物学学会积极响应中国细胞生物学学会细胞生物学教学与普及工作委员会的号召,2016年5月21日,永利集团88304官网在哈工大生命科学实验教学管理中心和生命科学院科研实验室,面向全市开展了主题为“接近‘生命’,热爱科学”的实验室开放活动,广大学生、家长及市民纷纷踊跃报名。
活动中趣味性科普的环节,在哈工大理学楼四楼生命科学实验教学管理中心进行。
参观者通过观察植物标本及切片、微生物菌种、斑马鱼、果蝇等实验材料,结合解说员的PPT演示和现场解说后,使用显微镜亲身体验了微观世界带来的不可思议的震撼。
实验项目 | 房间 | 设备 |
1. 显微镜观察微生物菌种 | 408 | 普通光学显微镜 |
2. 果蝇 | 406 | 体视显微镜 |
3. 植物标本、显微镜观察植物切片 | 404 | 普通光学显微镜 |
4. 荧光显微镜观察斑马鱼、PPT讲解 | 409 | 荧光显微镜 |
相关报道: | ||
校内通知 | “实验室开放日”活动通知 | |
黑龙江网络广播电视台 视频报道 | 哈工大实验室开放日 |
为响应中国科协加大科普活动力度的号召,提高公众科学素养,发挥学术团体的社会职能,增强学会的社会影响力,黑龙江省细胞生物学学会联合中国细胞生物学学会细胞生物学于2017年5月20日联合主办了2017年“实验室开放日”活动,由哈工大生命学院承办。
5月20日上午,负责活动现场老师和同学早早就到到达科学园和理学楼的场地做好了准备,迎接哈尔滨各中小学学生和家长们的到来。
本次活动包含趣味科普及科研实验室参观两个环节,实验教学中心承办其中第一环节——趣味性科普环节。
现场为参观者提供了植物标本及切片、微生物菌种、斑马鱼、果蝇等实验材料,讲解员们生动活泼地向参观者介绍了这些生物的习性、特点、在科研中的用途以及对科研起到的作用。随后,在操作员的帮助和带领下,参观者们亲身体验使用显微镜,感受到了镜下不一样的微观世界所带来的震撼。操作员们也有问必答,引起了参观者们更浓厚的兴趣,实验里不时传出孩子们兴奋的声音。这次活动的参观者中,有一些参加生物竞赛的高中生,他们与讲解员们进行了更为深入的探讨,了解了更多专业知识和实验室的具体工作内容。
本次活动受到哈尔滨市民的极大关注,现场,报社记者对讲解员们和家长孩子进行了采访,家长同学们纷纷表示在本次活动中受益匪浅,了解了更多与生活、科研方面相关的知识,也真正走近了实验室,希望能有更多类似的科普活动。
媒体报道:
纸媒 | 新华社:新华每日电讯 |
纸媒 | 哈尔滨日报、太原日报、大兴安岭日报 |
网媒 |
部分转载媒体:
哈尔滨市人民政府门户 | |
搜狐网 | |
哈工大新闻网 | |
东北网 | |
和讯网 |
为提高公众科学素养,发挥学术团体的社会职能,黑龙江省细胞生物学学会积极响应中国细胞生物学学会细胞生物学教学与普及工作委员会的号召,生命学院实验教学管理中心于5月27日面向全市开展2018年“实验室开放日”活动。广大师生家长踊跃报名参加。
本次活动以“神奇生物在身边”为主题,以趣味性的实验向参加者科学普及微生物的存在,唾液淀粉酶的影响以及生活中常常见到的昆虫——果蝇。
27日上午,负责活动现场老师和同学早早就到达科学园和理学楼的场地做好了准备,迎接哈尔滨各中小学学生和家长们的到来。
实验室现场,讲解员幽默风趣的讲解,操作员手把手引导参观者进行实验,领略生物学科与日常生活中的关联与美好。
相关报道: |
|
|
校内通知 | 哈工大生命学院2018年“实验室开放日”活动公告 | http://today2.hit.edu.cn/news/2018/05-24/9265010150RL0.htm |